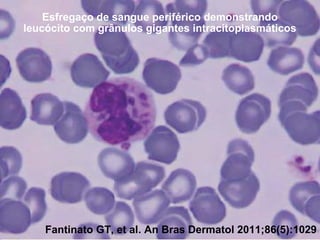
Esfregaço de sangue periférico demonstrando
leucócito com grânulos gigantes intracitoplasmáticos

Síndrome de Chédiak-Higashi

Fantinato GT, et al. An Bras Dermatol 2011;86(5):1029
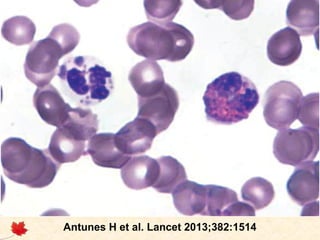
Síndrome de Chédiak-Higashi

Antunes H et al. Lancet 2013;382:1514
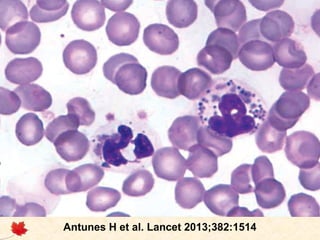
Síndrome de Chédiak-Higashi

Antunes H et al. Lancet 2013;382:1514
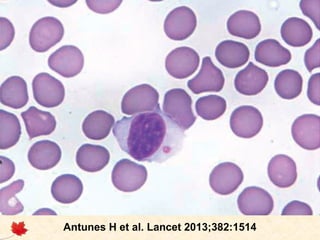
Síndrome de Chédiak-Higashi

Antunes H et al. Lancet 2013;382:1514

A síndrome de Chédiak-Higashi é uma doença hereditária rara caracterizada por grânulos gigantes em diversas células do corpo e disfunção celular, resultando em albinismo parcial, infecções recorrentes, sangramentos e neuropatia. O diagnóstico é frequentemente realizado em crianças e a única cura é o transplante de células-tronco, que evita a fase acelerada da doença, enquanto o tratamento clínico envolve abordagens para controlar infecções e outras manifestações. A evolução da síndrome pode ser severa, especialmente na forma precoce, onde muitos pacientes falecem na infância sem tratamento adequado.